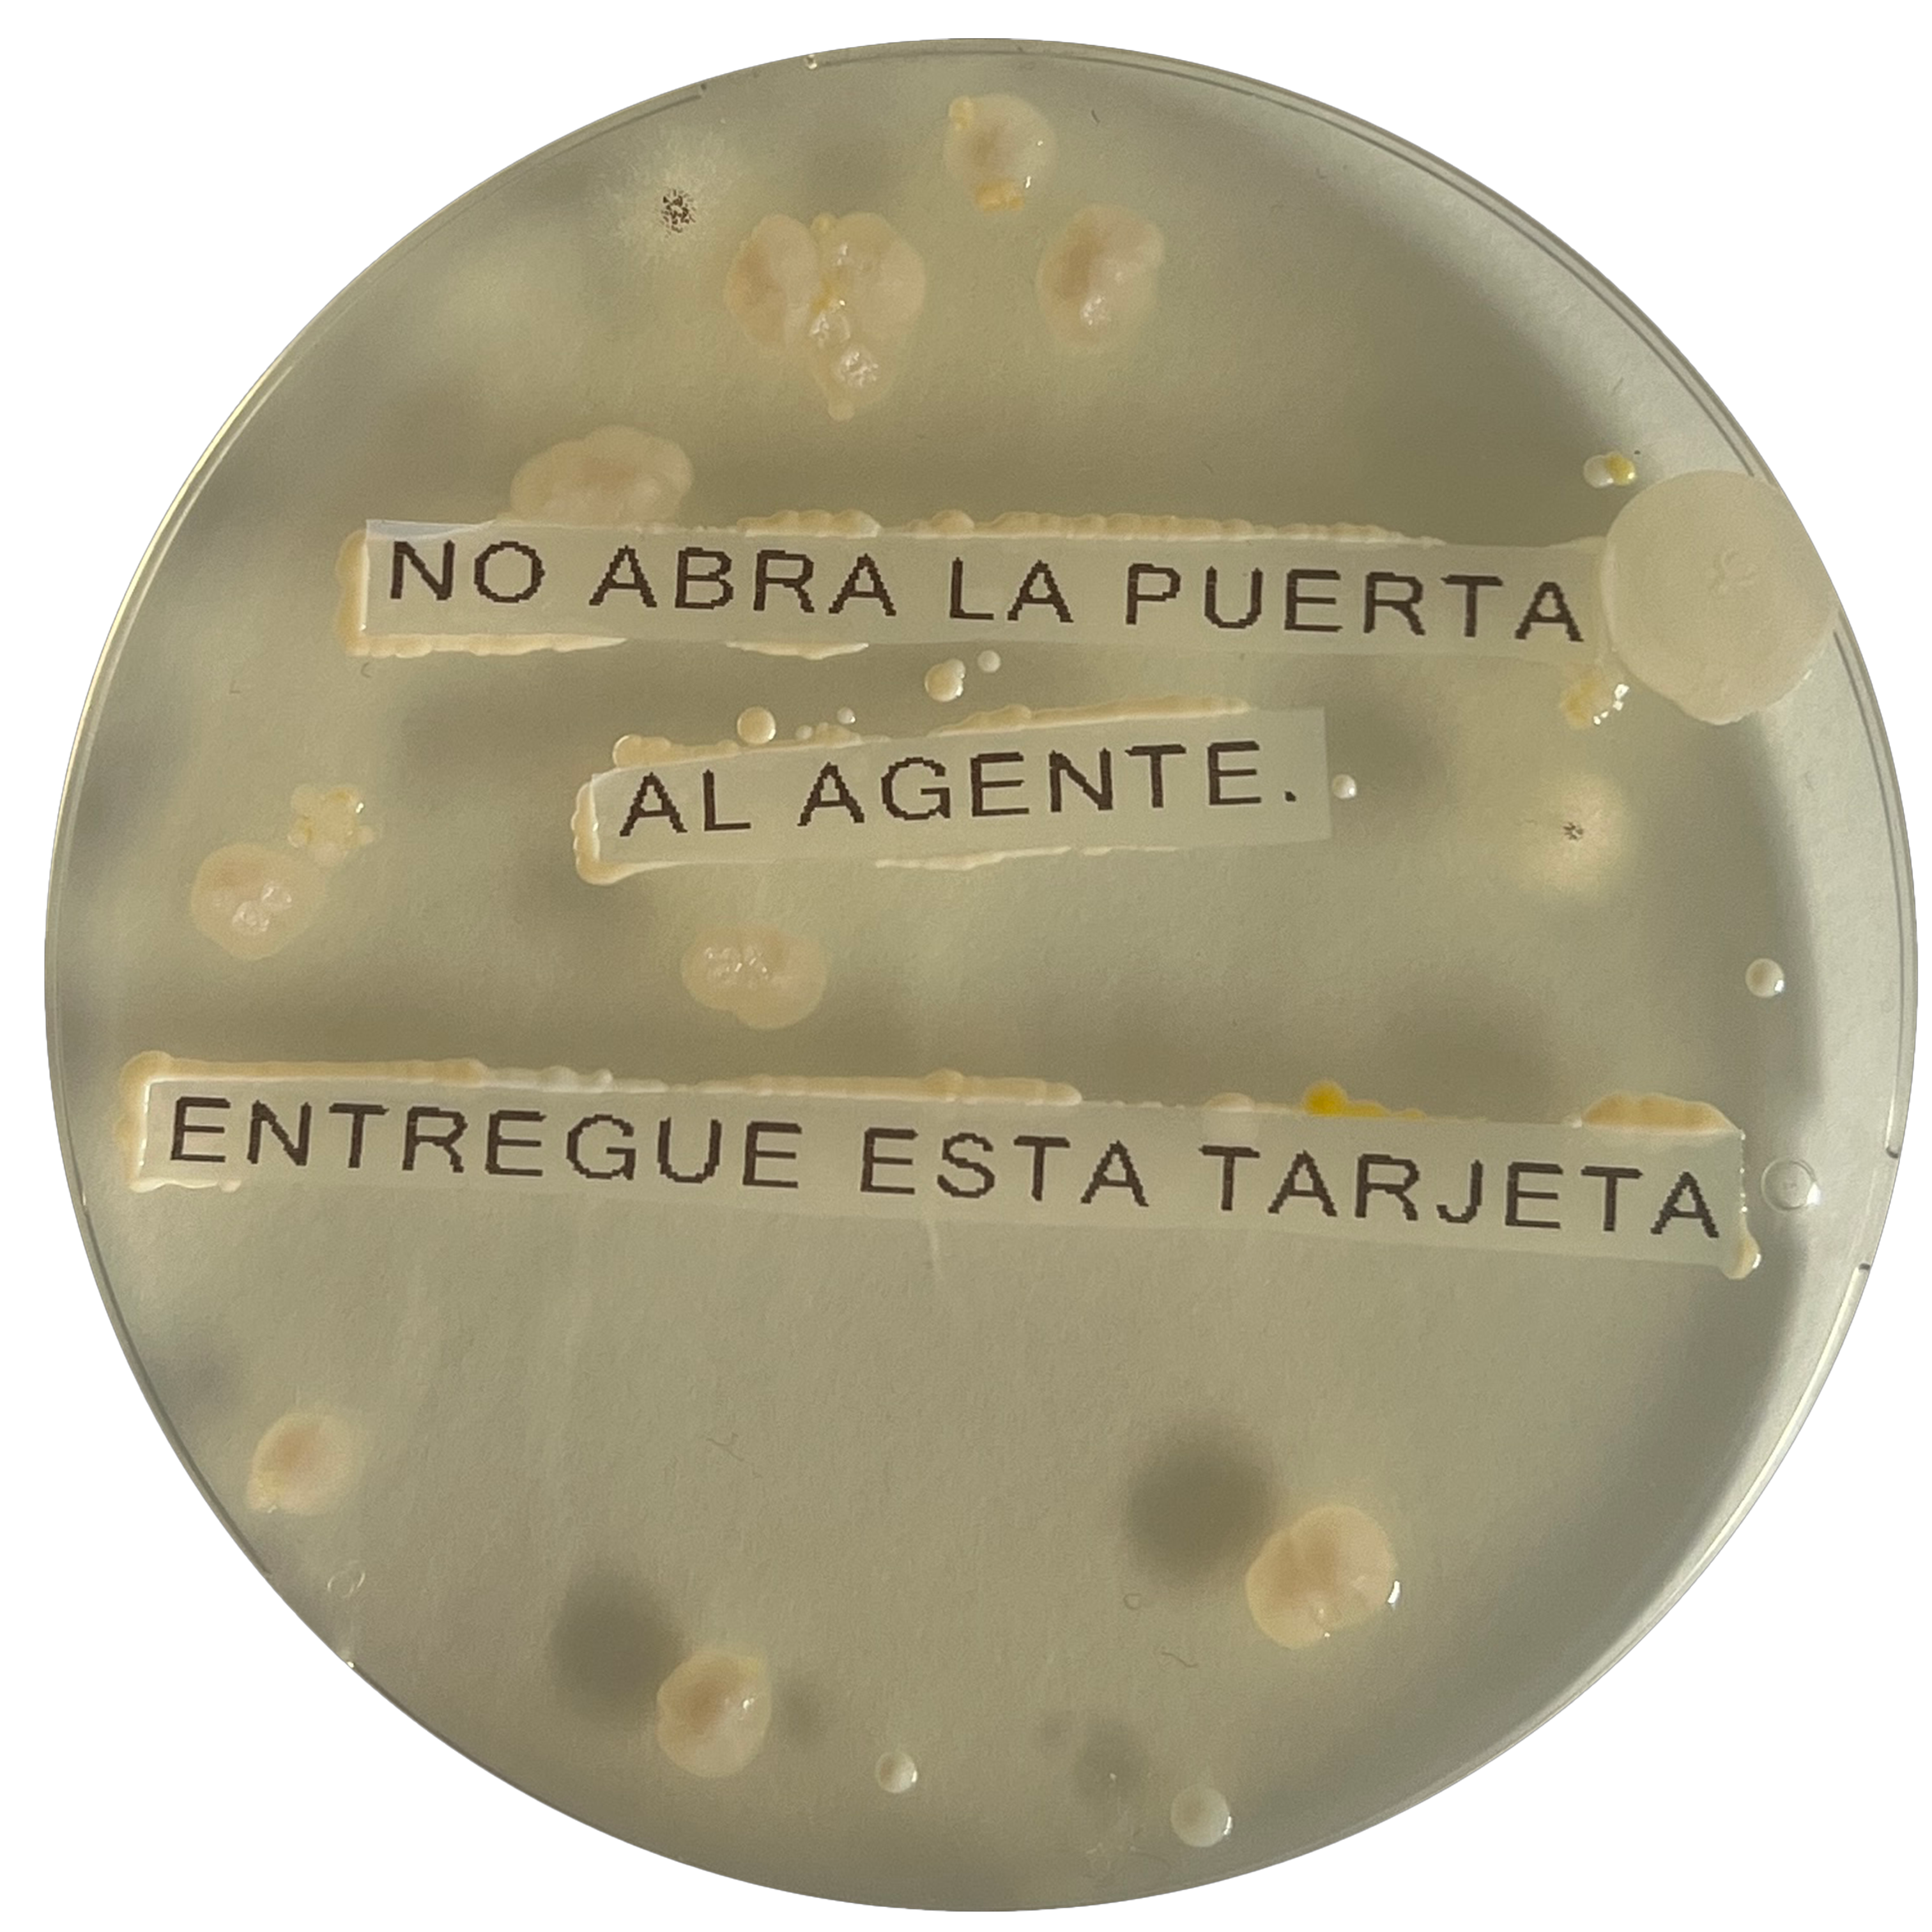
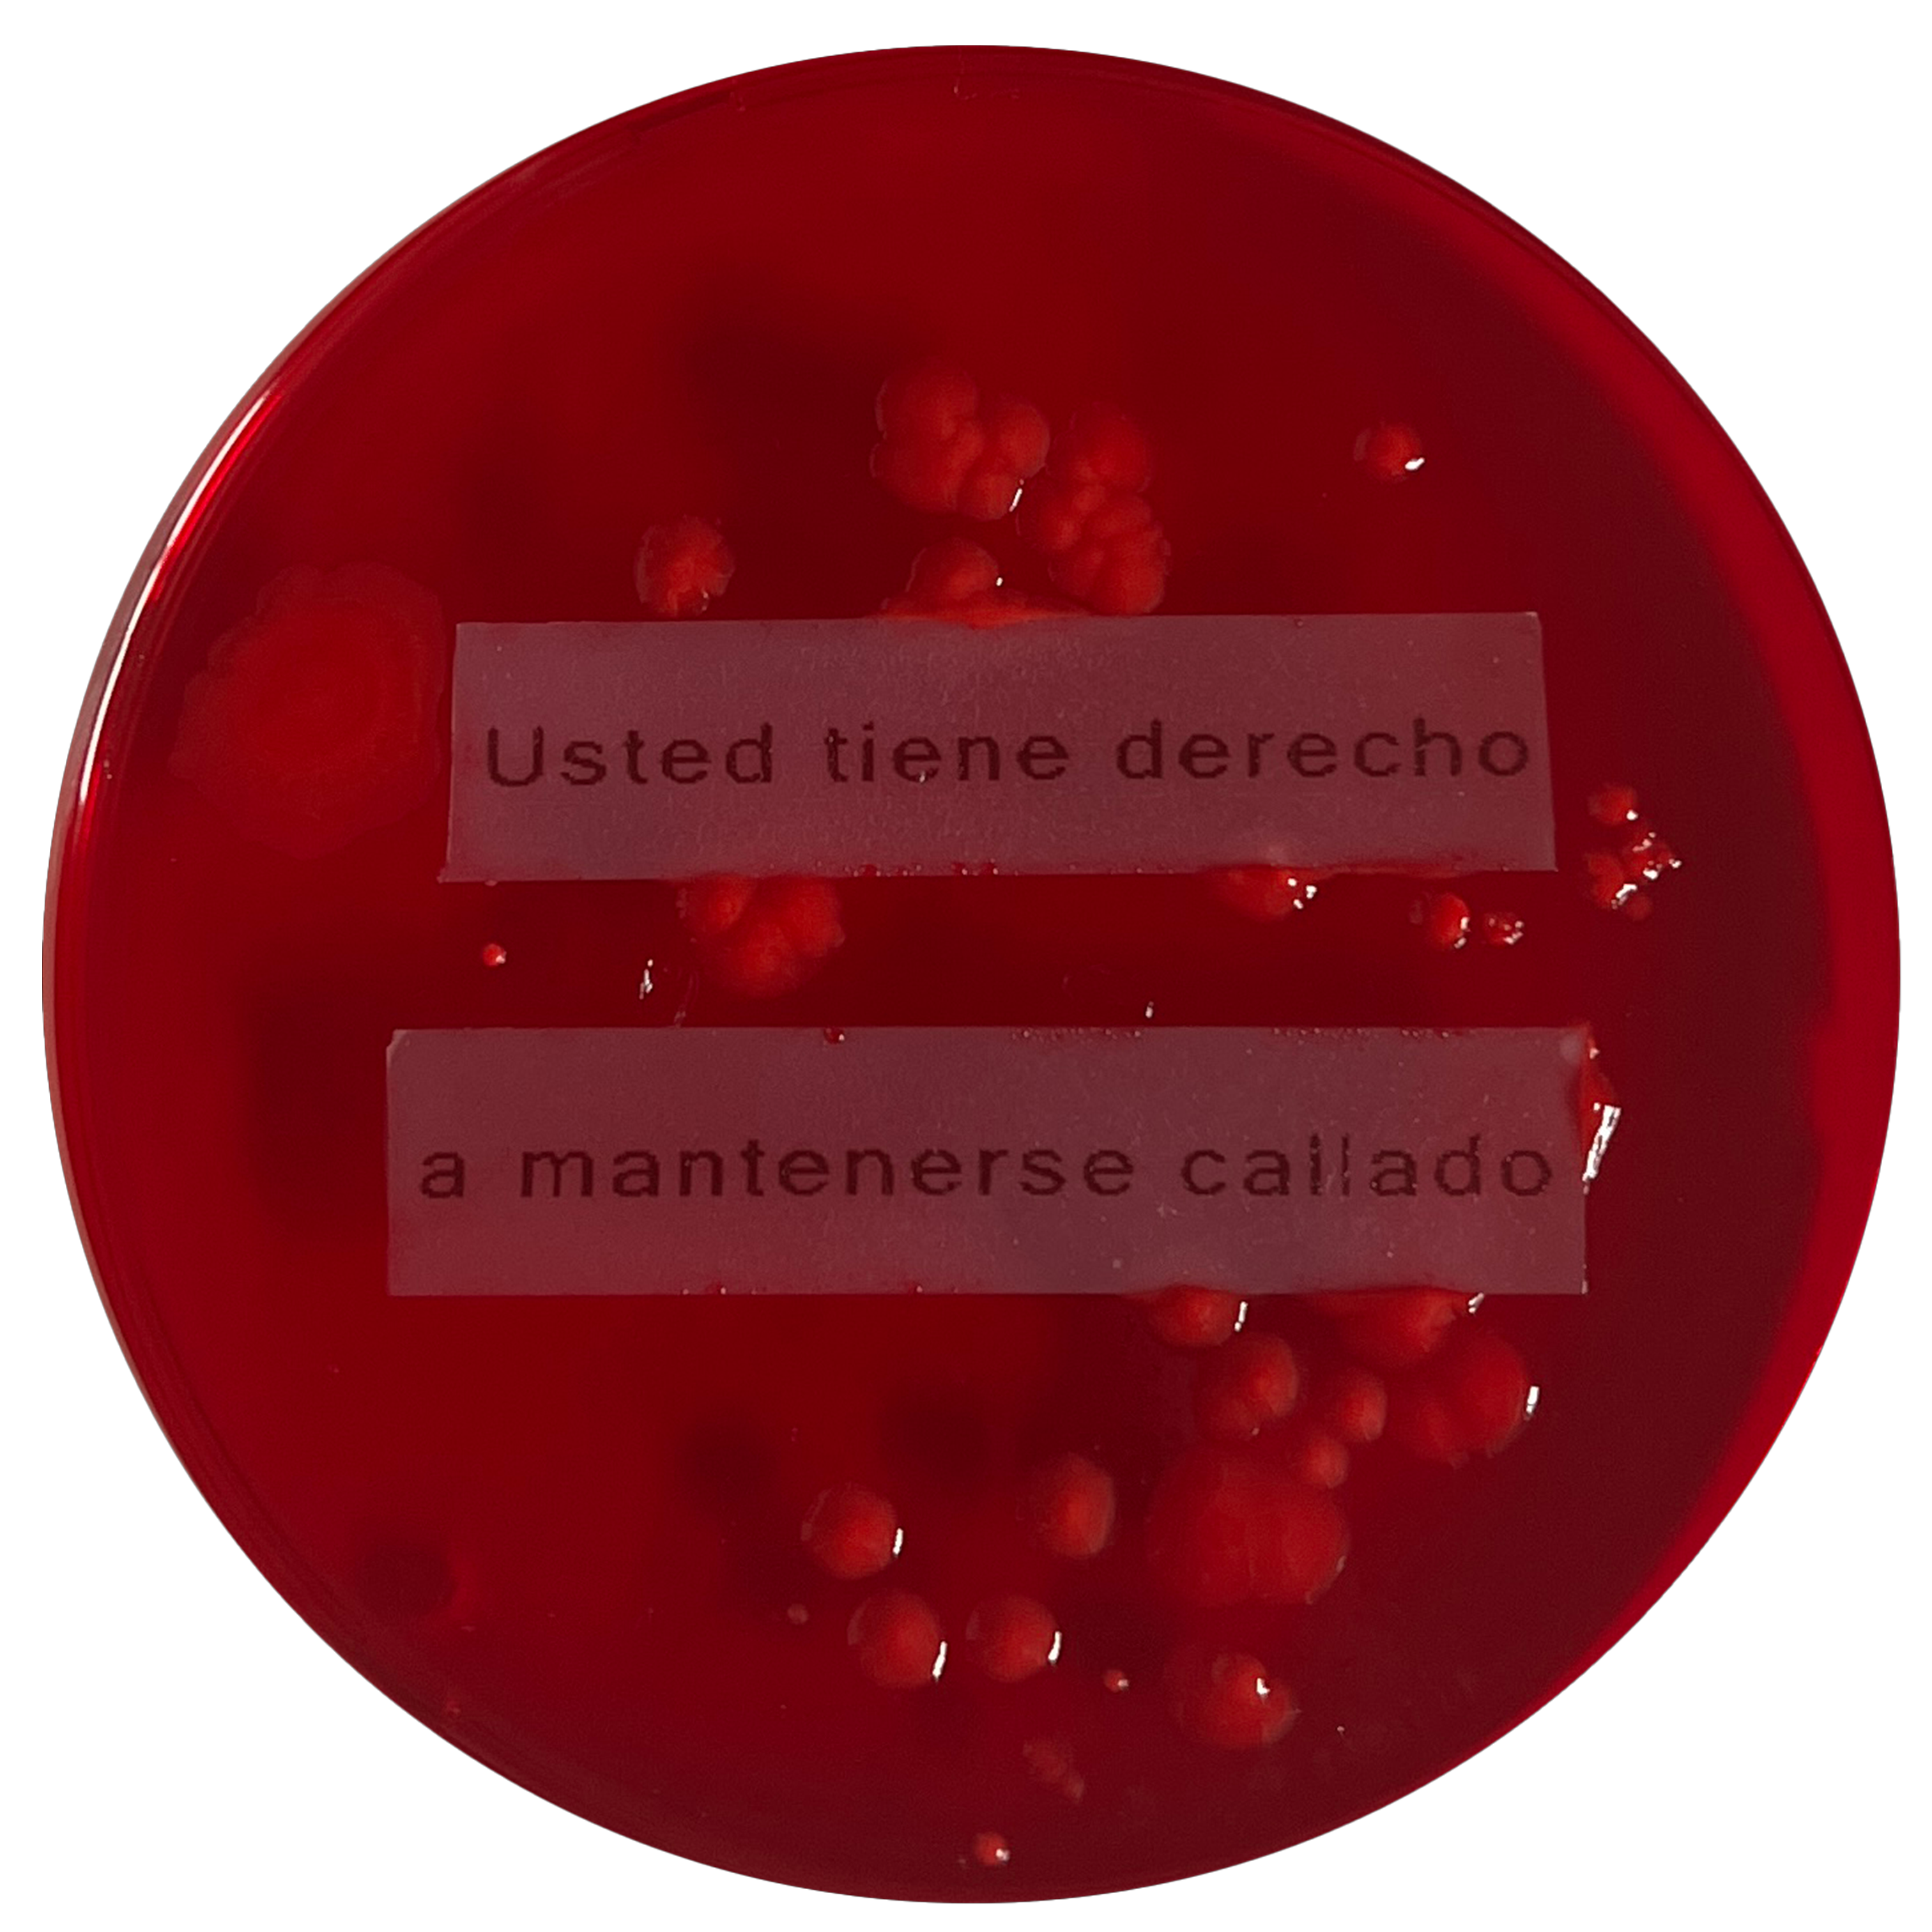
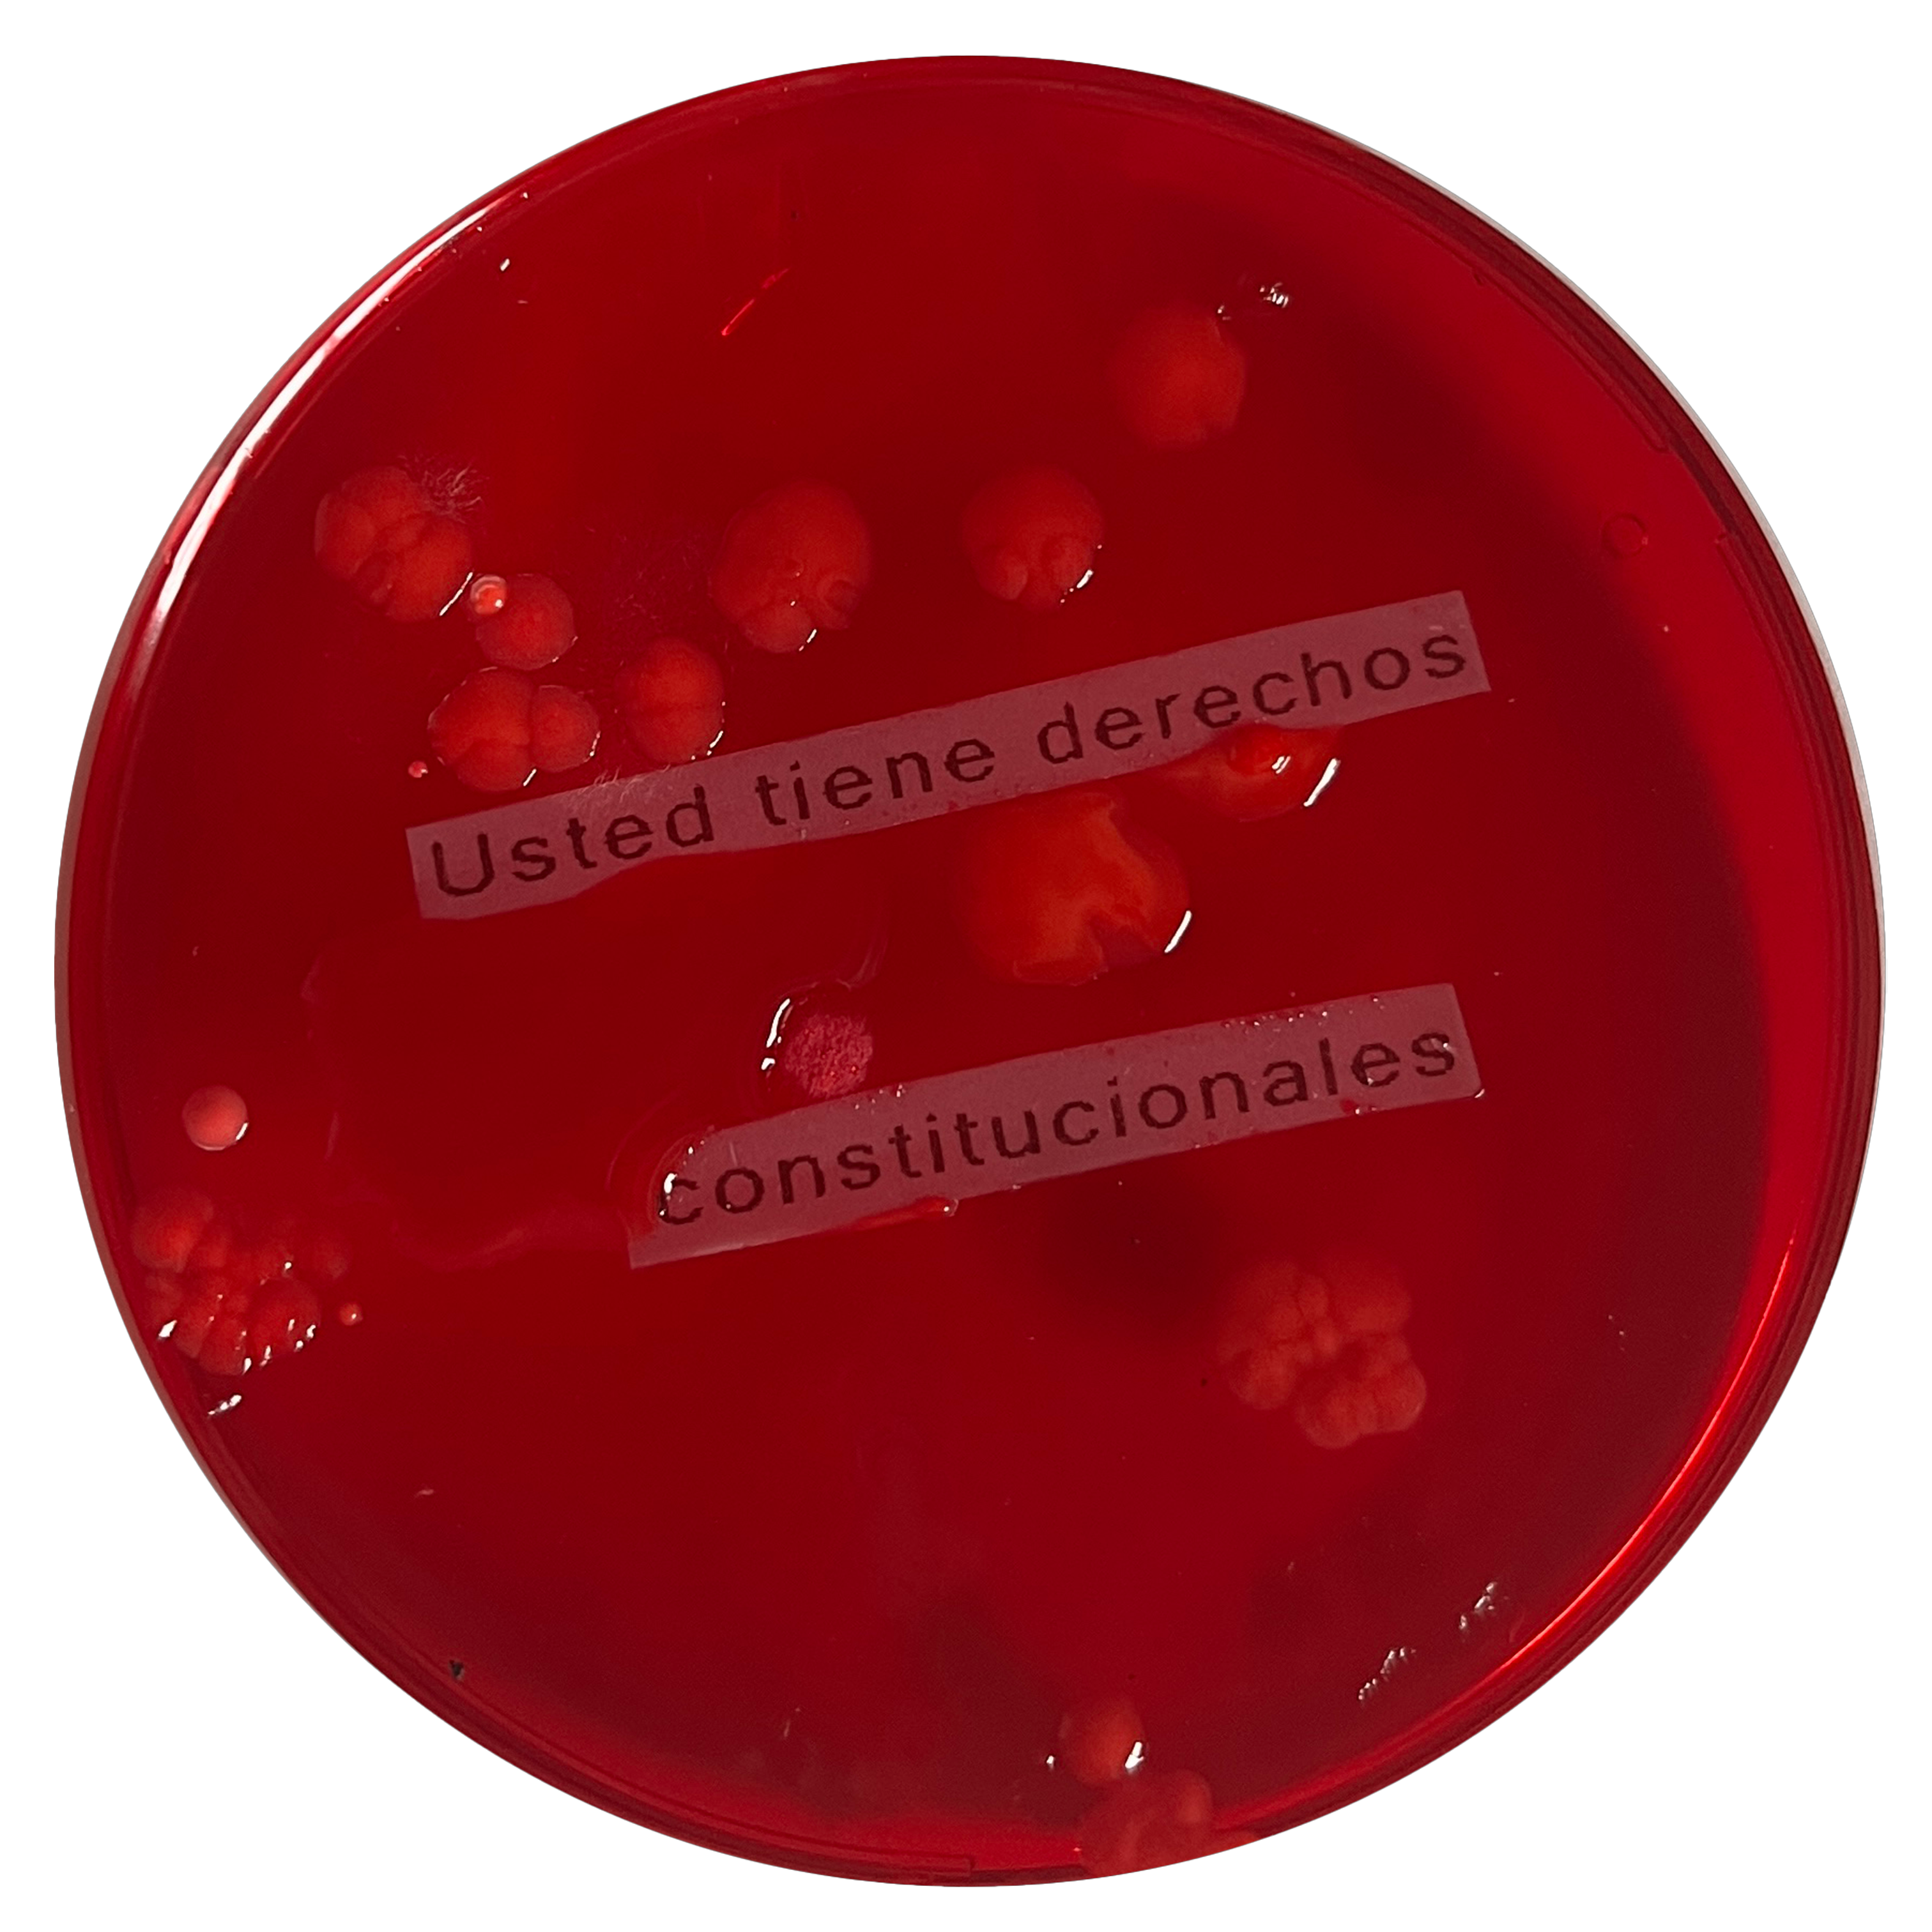
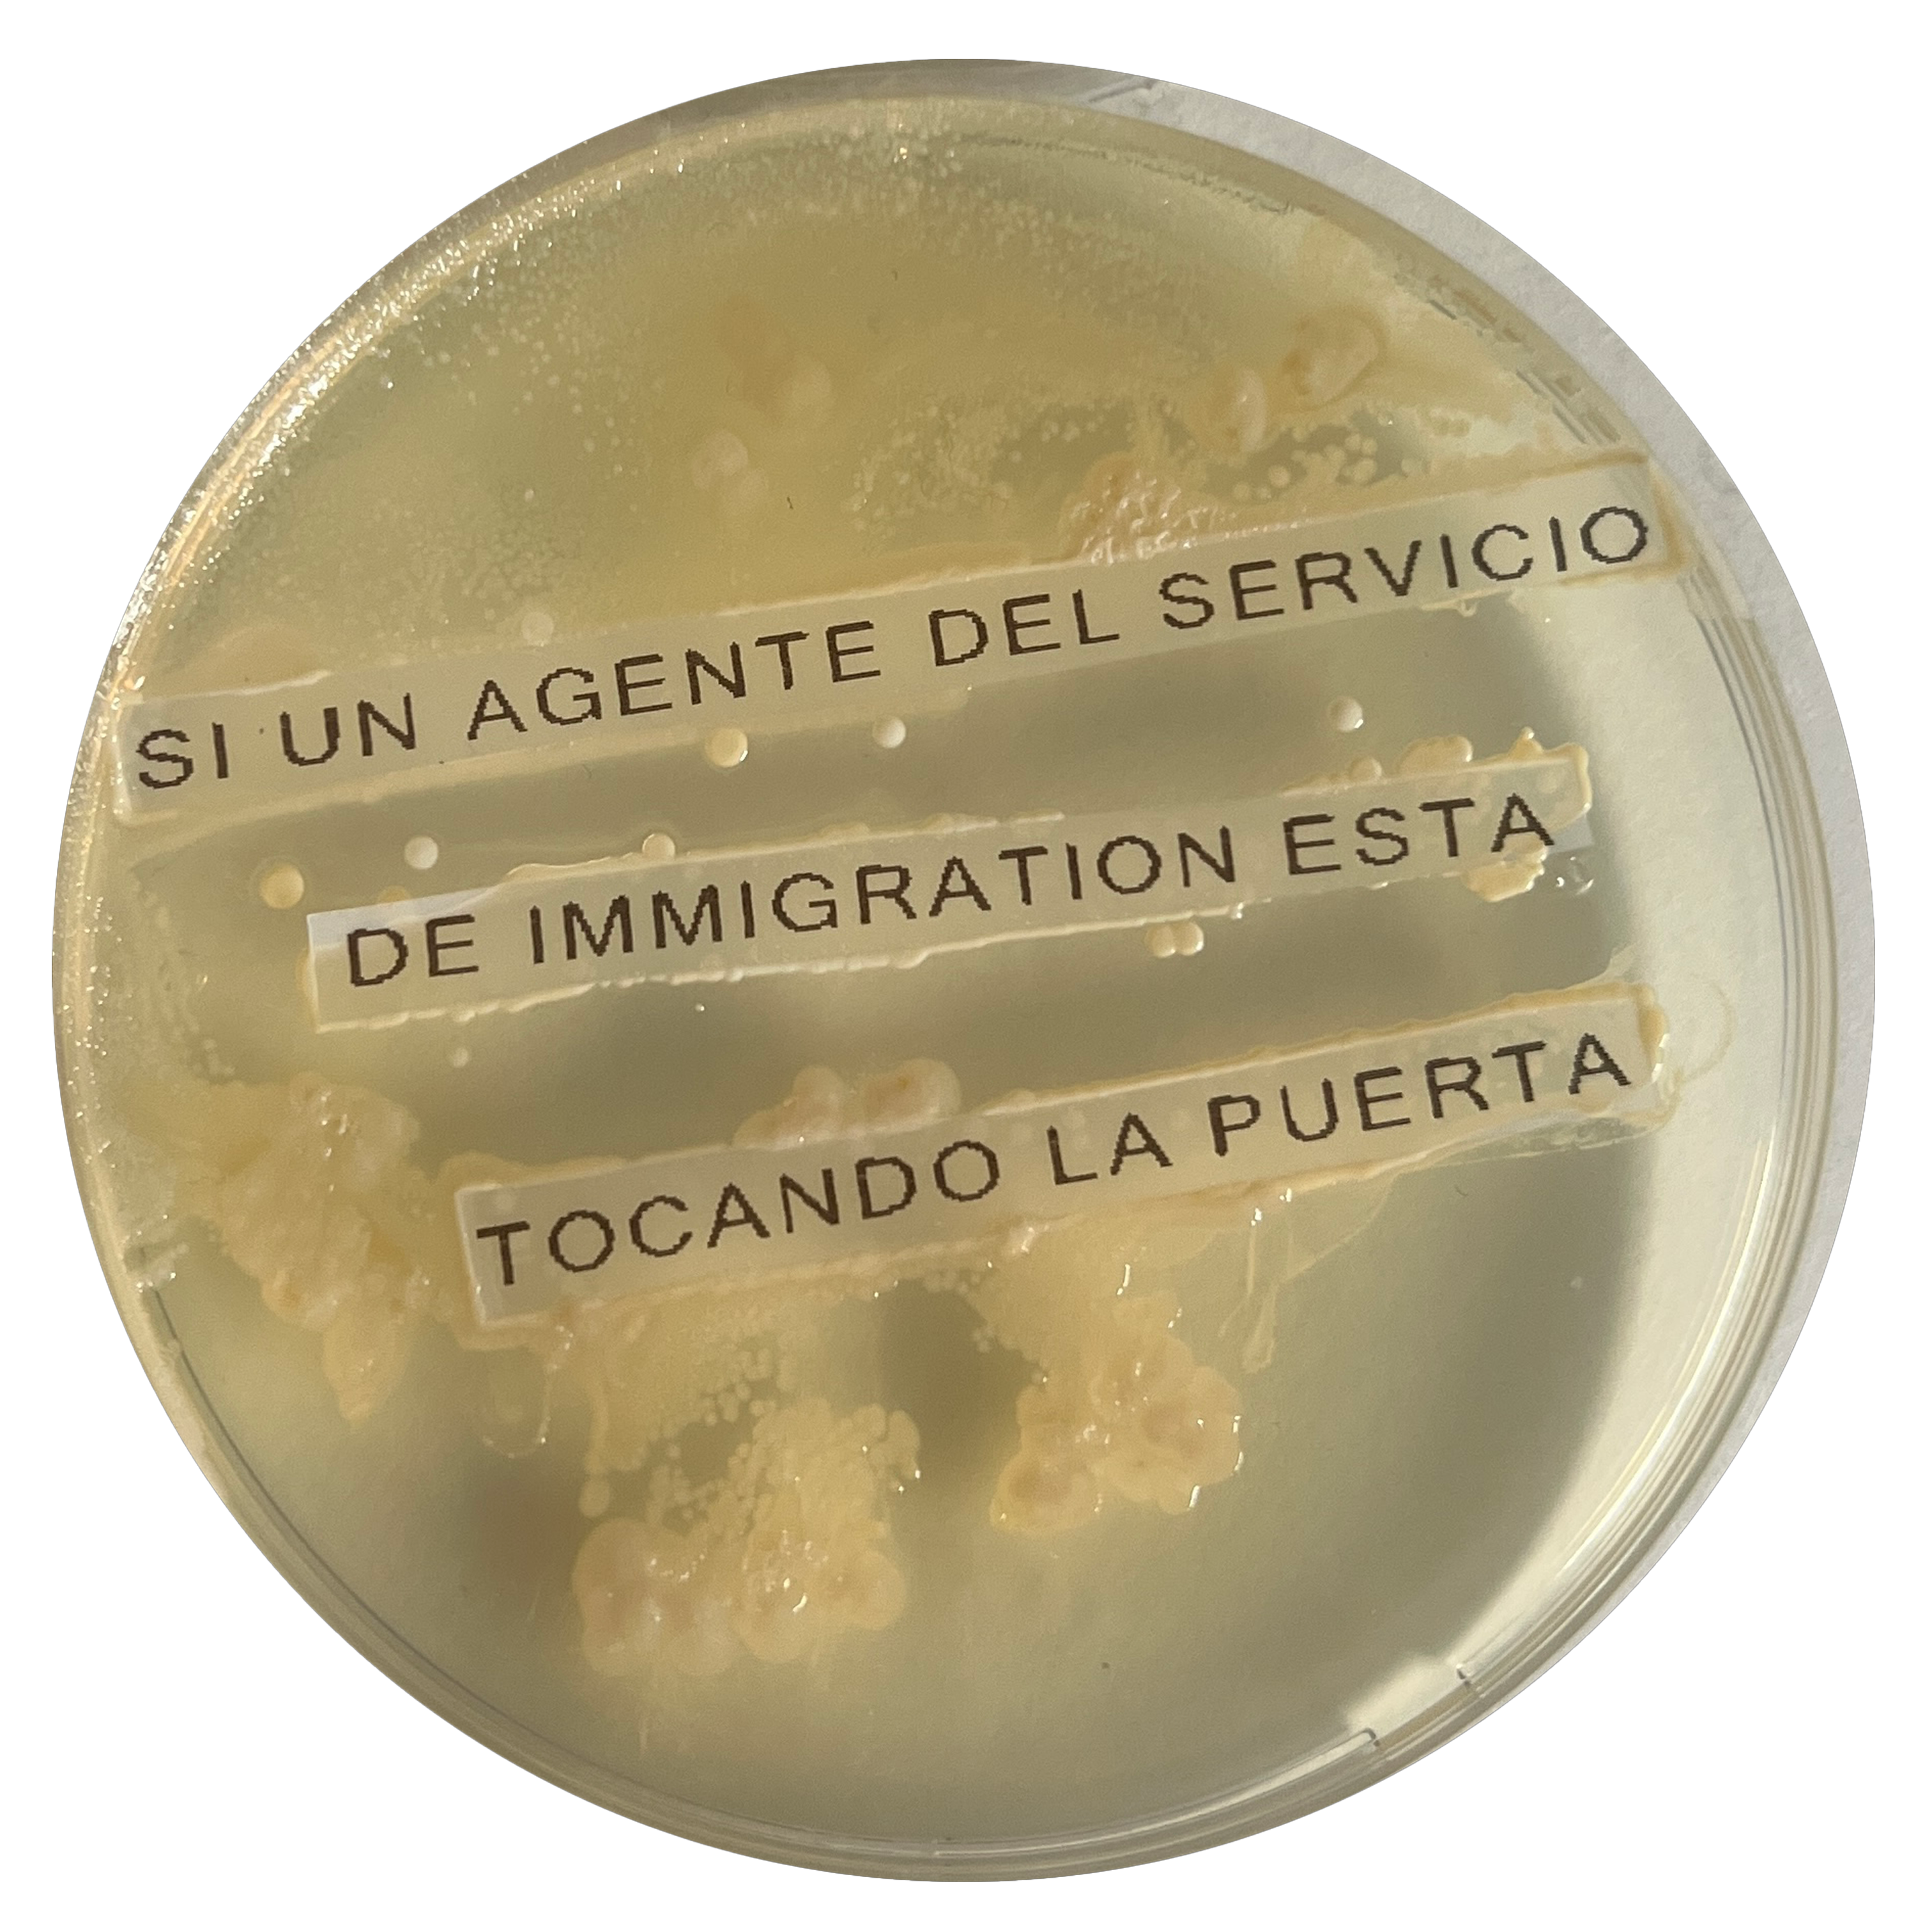

Day 4
DO NOT OPEN THE DOOR TO THE AGENT. HAND OVER THIS CARD
Day 4
YOU HAVE THE RIGHT TO REMAIN SILENT.
Day 4

DO NOT OPEN THE DOOR.
Day 4
YOU HAVE CONSTITUTIONAL RIGHTS.
Day 4
IF AN IMMIGRATION AGENT IS KNOCKING ON THE DOOR